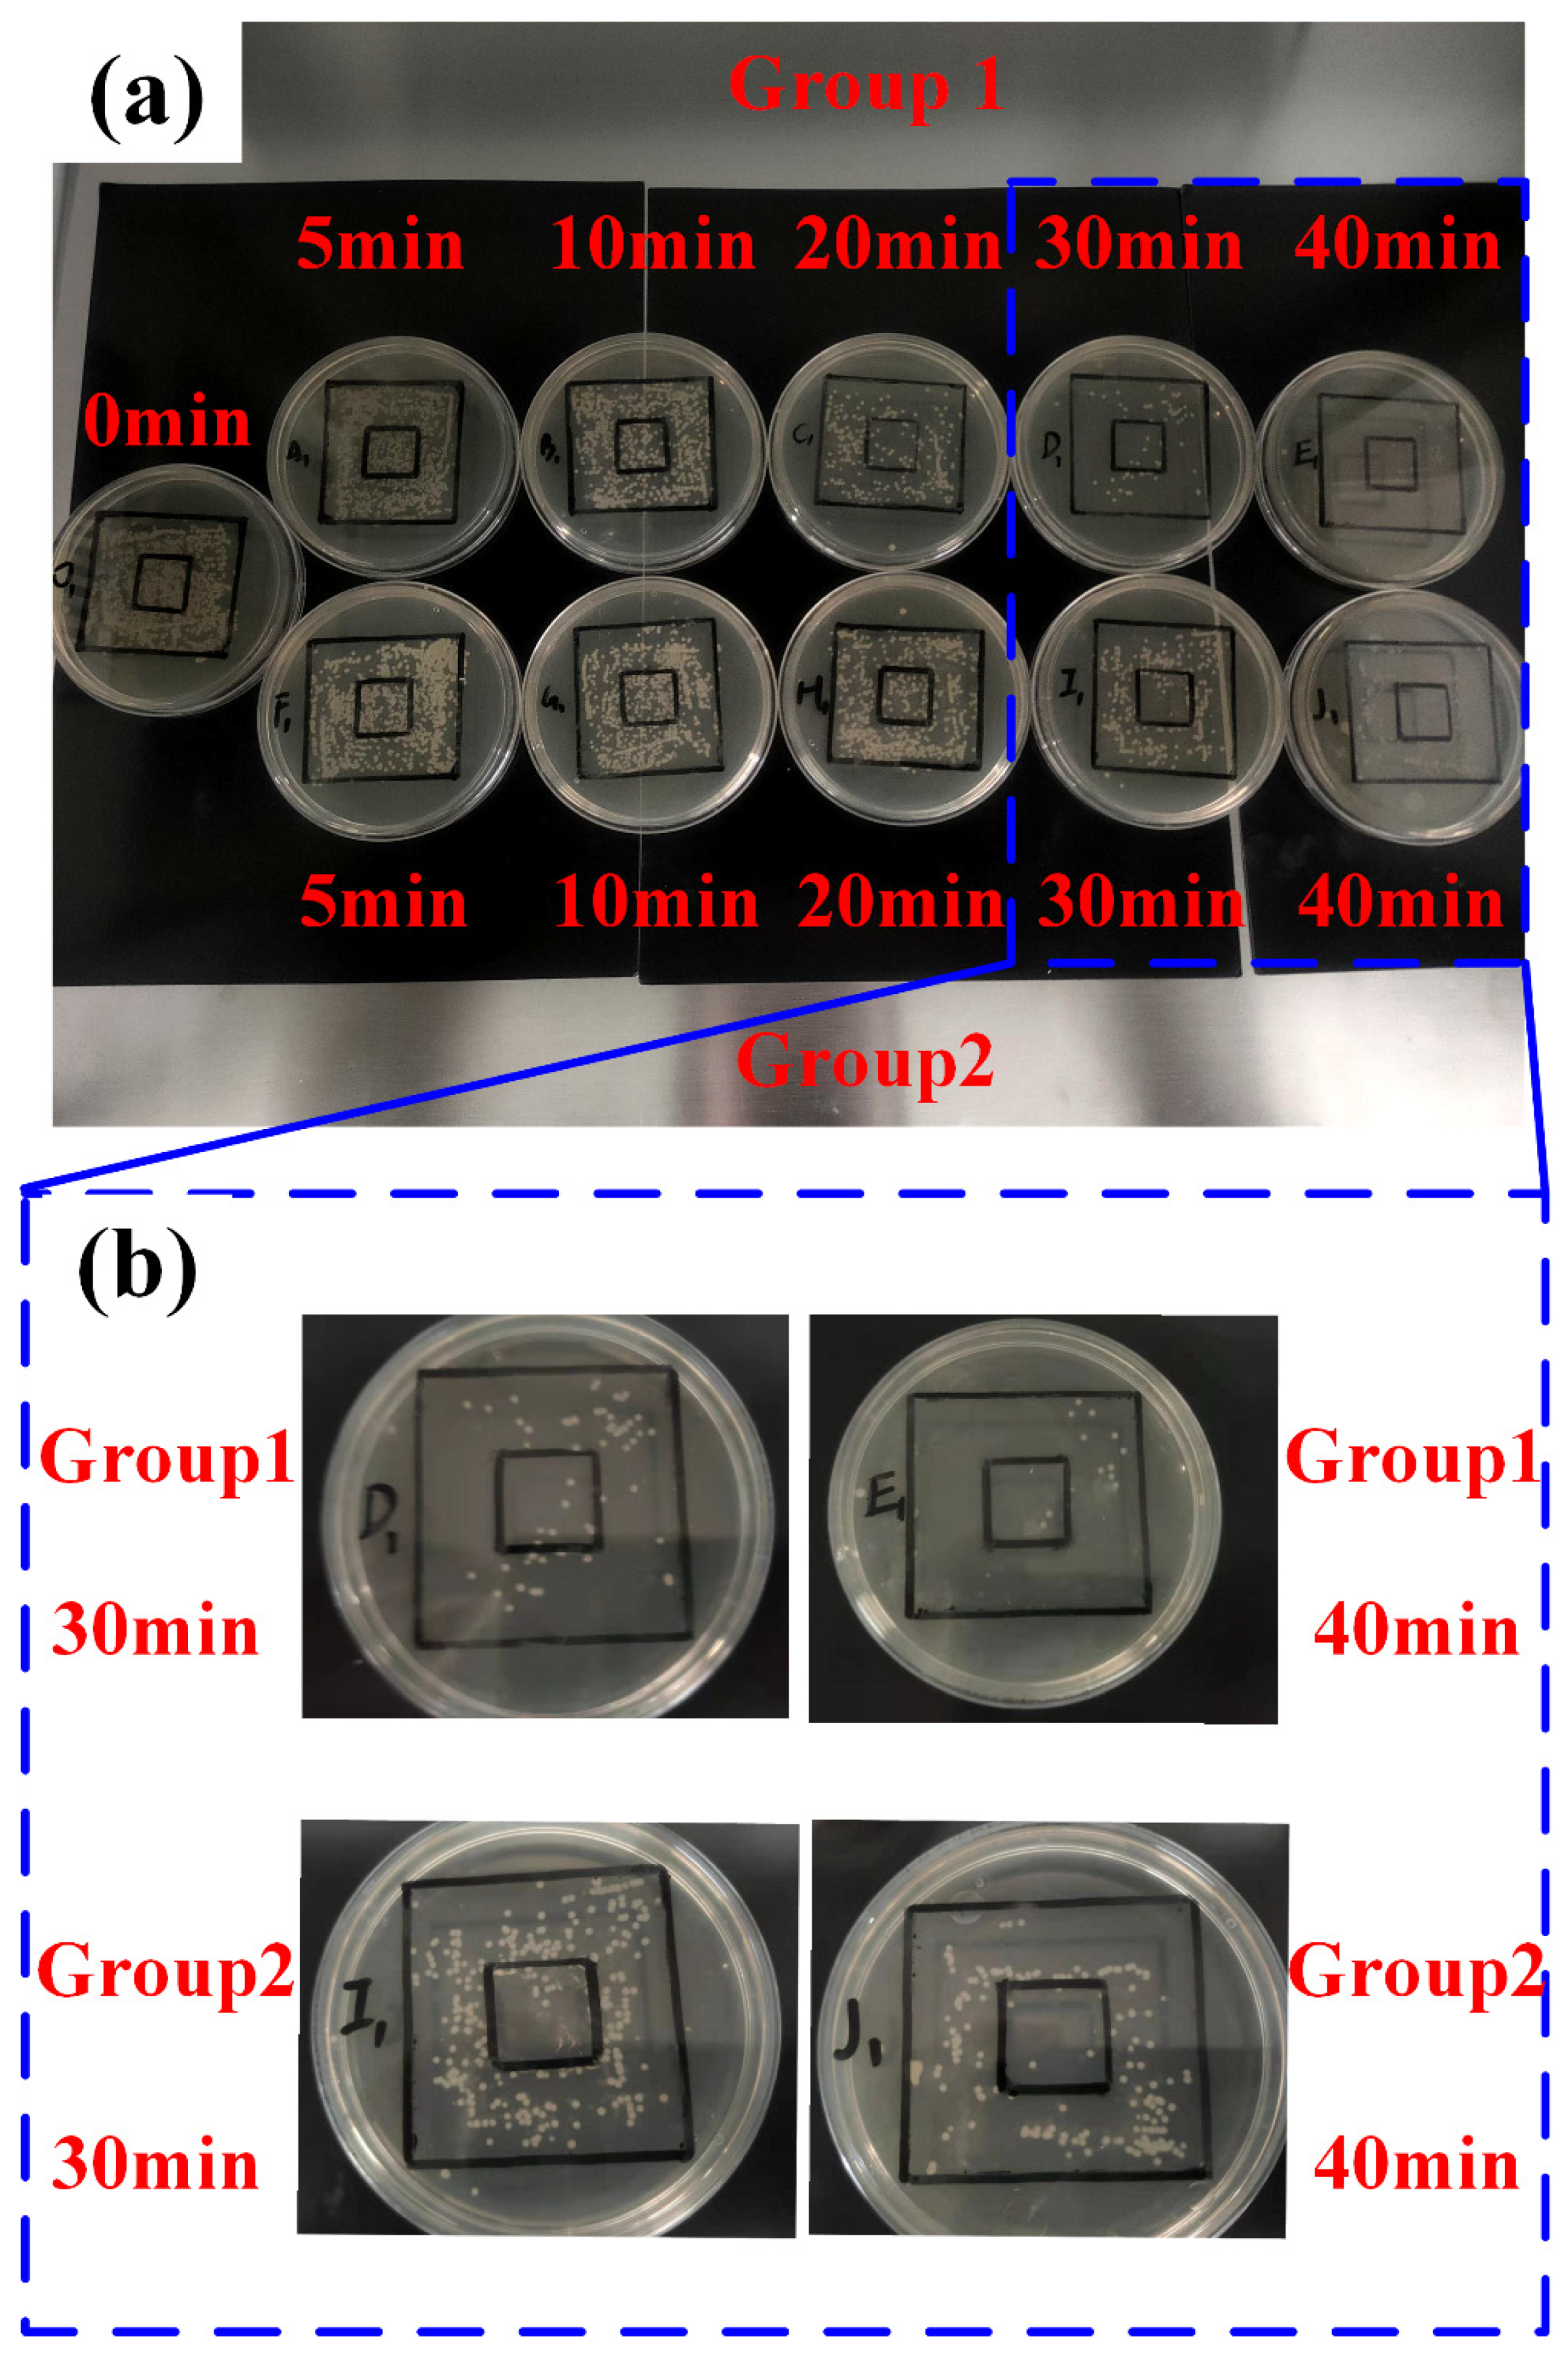
Applsci 12 01285 g007

Study on the Light Field Regulation of UVC-LED Disinfection for Cold Chain Transportation
Abstract
:1. Introduction
2. Background
3. Research Methodology
3.1. Simulation Modeling of Ice Influence
3.2. Design of the Proposed Optical System
3.3. The Preparation of the Experiments
4. Results
4.1. Results of Simulations on Ice Influence
4.2. Simulation of the Proposed Optical System
4.3. Results of Experiments
5. Discussion
6. Conclusions
Author Contributions
Funding
Institutional Review Board Statement
Informed Consent Statement
Data Availability Statement
Conflicts of Interest
Abbreviation
| Abbreviation | Detailed meaning |
| UVC | Ultraviolet C |
| LED | Light Emitting Diode |
| E. coli | Escherichia coli |
| COVID-19 | Corona Virus Disease 2019 |
| CAP | Cold atmospheric plasma |
| DUV | Deep-Ultraviolet |
| LP-UV | Low-pressure mercury UV |
| TCID50 | 50% Tissue culture infectivedose |
References
- Pang, X.; Ren, L.; Wu, S.; Ma, W.; Yang, J.; Di, L.; Li, J.; Xiao, Y.; Kang, L.; Du, S.; et al. Cold-chain food contamination as the possible origin of COVID-19 resurgence in Beijing. Natl. Sci. Rev. 2020, 7, 1861–1864. [Google Scholar] [CrossRef] [PubMed]
- Zhang, X. COVID-19 transmission in cold chain: A safe and green new-generation cold chain is demanded. Int. J. Energy Res. 2021, 45, 6483–6488. [Google Scholar] [CrossRef]
- Van Doremalen, N.; Bushmaker, T.; Morris, D.; Holbrook, M.; Gamble, A.; Williamson, B.; Tamin, A.; Harcourt, J.; Thornburg, N.; Gerber, S.; et al. Aerosol and surface stability of SARS-CoV-2 as compared with SARS-CoV-1. N. Engl. J. Med. 2020, 382, 1564–1567. [Google Scholar] [CrossRef] [PubMed]
- Chan, K.; Marlik Peiris, J.; Lam, S.; Poon, N.; Yuen, K.; Seto, W. The effects of temperature and relative humidity on the viability of the SARS coronavirus. Adv. Virol. 2011, 2011, 734690. [Google Scholar] [CrossRef] [PubMed]
- Chen, Z.; Garcia, G.; Arumugaswami, V.; Wirz, R. Cold atmospheric plasma for SARS-CoV-2 inactivation. Phys. Fluids 2020, 32, 111702. [Google Scholar] [CrossRef]
- Zhang, H.; Chen, M.; Huang, L.; Guo, L.; Xu, S.; Zhang, J.; Xi, W.; Wang, Z.; Liu, D.; Kong, M. Using cold atmospheric plasma treated-air for COVID-19 disinfection in cold-chain environment. J. Phys. D Appl. Phys. 2021, 54, 40LT01. [Google Scholar] [CrossRef]
- Koutchma, T. Advances in ultraviolet light technology for non-thermal processing of liquid foods. Food Bioprocess Technol. 2009, 2, 138–155. [Google Scholar] [CrossRef]
- Zeqiri, B.; Hodnett, M.; Carroll, A. Studies of a novel sensor for assessing the spatial distribution of cavitation activity within ultrasonic cleaning vessels. Ultrasonics 2006, 44, 73–82. [Google Scholar] [CrossRef]
- Shin, J.; Kim, S.; Kim, D.; Kang, D. Fundamental characteristics of deep-UV light-emitting diodes and their application to control foodborne pathogens. Appl. Environ. Microbiol. 2016, 82, 2–10. [Google Scholar] [CrossRef] [Green Version]
- Liang, J.; Liao, C.; Chang, C.; Lee, C.; Chen, S.; Huang, S.; Yeh, Y.; Singh, K.; Kuo, H.; Lin, Y.; et al. The Effectiveness of far-ultraviolet (UVC) light prototype devices with different wavelengths on disinfecting SARS-CoV-2. Appl. Sci. 2021, 11, 10661. [Google Scholar] [CrossRef]
- Heilinglog, C.; Aufderhorst, U.; Schipper, L.; Dittmer, U.; Witzke, O.; Yang, D.; Zhang, X.; Sutter, K.; Trilling, M.; Alt, M.; et al. Susceptibility of SARS-CoV-2 to UV irradiation. Am. J. Infect. Control 2020, 48, 1273–1275. [Google Scholar] [CrossRef] [PubMed]
- Kitagawa, H.; Nomura, T.; Nazmul, T.; Keitaro, O.; Shigemoto, N.; Sakaguchi, T.; Ohge, H. Effectiveness of 222-nm ultraviolet light in disinfection SARS-CoV-2 surface contamination. Am. J. Infect. Control 2020, 49, 299–301. [Google Scholar] [CrossRef] [PubMed]
- Liang, S.; Hao, R.; Fan, D.; Li, B.; Huang, J.; Zhang, Y.; Wu, J.; Li, Y.; Mo, J. Structural optimization and numerical thermal analysis of ultraviolet light-emitting diodes with high-power multi-chip arrays. Optik 2020, 222, 165333. [Google Scholar] [CrossRef]
- Buonanno, M.; Welch, D.; Shuryak, I.; Brenner, D. Far-UVC light (222 nm) efficiently and safely inactivates airborne human coronaviruses. Sci. Rep. 2020, 10, 10285. [Google Scholar] [CrossRef] [PubMed]
- Chawla, A.; Lobacz, A.; Tarapata, J.; Zulewska, J. UV light application as a mean for disinfection applied in the dairy industry. Appl. Sci. 2021, 11, 7285. [Google Scholar] [CrossRef]
- Bačík, J.; Tkáč, P.; Hric, L.; Alexovič, S.; Kyslan, K.; Olexa, R.; Perduková, D. Phollower—The universal autonomous mobile robot for industry and civil environments with COVID-19 germicide addon meeting safety requirements. Appl. Sci. 2020, 10, 7682. [Google Scholar] [CrossRef]
- Shen, L.; Grilffith, T.; Nyangaresi, P.; Qin, Y.; Pang, X.; Chen, G.; Li, M.; Lu, Y.; Zhang, B. Efficacy of UVC-LED in water disinfection on Bacillus species with consideration of antibiotic resistance issue. J. Hazard. Mater. 2020, 386, 121968. [Google Scholar] [CrossRef]
- Shatalov, M.; Sun, W.; Jain, R.; Lunev, A.; Hu, X.; Dobrinsky, A.; Bilenko, Y.; Yang, J.; Garrett, G.; Rodak, L.; et al. High power AlGaN ultraviolet light emitters. Semicond. Sci. Technol. 2014, 29, 084007. [Google Scholar] [CrossRef]
- Shur, M.; Gaska, R. Deep-ultraviolet light-emitting diodes. IEEE Trans. Electron Devices 2010, 57, 12–25. [Google Scholar] [CrossRef]
- Tamulaitis, G. Ultraviolet light emitting diodes. Lith. J. Phys. 2011, 51, 177–193. [Google Scholar] [CrossRef] [Green Version]
- Muramoto, Y.; Kimura, M.; Nouda, S. Development and future of ultraviolet light-emitting diodes: UV-LED will replace the UV lamp. Semicond. Sci. Technol. 2014, 29, 084004. [Google Scholar] [CrossRef] [Green Version]
- Djavid, M.; Mi, Z. Enhancing the light extraction efficiency of AlGaN deep ultraviolet light emitting diodes by using nanowire structures. Appl. Phys. Lett. 2016, 108, 051102. [Google Scholar] [CrossRef]
- Ryu, H.; Choi, I.; Choi, H.; Shim, J. Investigation of light extraction efficiency in AlGaN deep ultraviolet light-emitting diodes. Appl. Phys. Express 2013, 6, 062101. [Google Scholar] [CrossRef]
- Adivarahan, V.; Sun, W.; Chitnis, A.; Shatalov, M.; Wu, S.; Maruska, H.; Khan, M. 250 nm AlGaN light-emitting diodes. Appl. Phys. Lett. 2004, 85, 2175–2177. [Google Scholar] [CrossRef]
- Wu, S.; Adivarahan, V.; Shatalov, M.; Chitnis, A.; Sun, W.; Khan, M. Micro-pixel design milliwatt power 254 nm emission light emitting diodes. Jpn. J. Appl. Phys. 2004, 43, 8–11. [Google Scholar] [CrossRef]
- Zhen, Z.; Xiang, H.; Xu, L. Freeform surface lens for LED uniform illumination. Appl. Optics 2009, 48, 6627–6634. [Google Scholar]
- Ding, Y.; Liu, X.; Zheng, Z.; Gu, P. Secondary optical design for LED illumination using freeform lens. Illum. Opt. 2008, 7103, 71030K. [Google Scholar]
- Tai, W.; Schwarte, R. Design of an aspherical lens to generate a homogenous irradiance for three-dimensional sensors with a light-emitting-diode source. Appl. Opt. 2000, 39, 5801. [Google Scholar] [CrossRef]
- Liu, P.; Guan, Z.; Zhou, T.; Xie, Q.; Yu, Q.; He, Y.; Zeng, Z.; Wang, X. Laser regulation for variable color temperature lighting with low energy consumption by microlens arrays. Appl. Opt. 2021, 60, 5652–5661. [Google Scholar] [CrossRef]

| Lens | Lens 1 | Lens 2 | Lens 3 | Lens 4 | Lens 5 |
|---|---|---|---|---|---|
| Type | Standard Lens | Standard Lens | Standard Lens | Microlens Array | Standard Lens |
| X Half-Width | / | / | / | 0.5 | / |
| Y Half-Width | / | / | / | 0.5 | / |
| Clear 1 | 1.53 | 4.01 | 8.06 | / | 10.0 |
| Clear 2 | 1.53 | 5.36 | 8.44 | / | 10.0 |
| Thickness | 0.3 | 4.0 | 4.0 | 1.0 | 6.0 |
| Radius 1 | 0 | −6.9 | −76.32 | −1.2 | 30.0 |
| Conic 1 | 0 | 0 | 0 | 0.5 | 0 |
| Radius 2 | 0 | −5.5 | −20.0 | 0 | −30.0 |
| Conic 2 | 0 | 0 | 0 | 0 | 0 |
| Times | Group 1 (in) | Group 1 (out) | Group 1 (Total) | Group 2 (in) | Group 2 (out) | Group 2 (Total) |
|---|---|---|---|---|---|---|
| 0 min | 254.00 | 937.00 | 1191.00 | 254.00 | 937.00 | 1191.00 |
| 5 min | 203.33 | 764.67 | 968.00 | 215.33 | 859.00 | 1074.33 |
| 10 min | 127.33 | 465.67 | 593 | 131.67 | 644.67 | 776.33 |
| 20 min | 43.33 | 197.00 | 240.33 | 63.00 | 543.00 | 606.00 |
| 30 min | 9.67 | 47.67 | 57.33 | 28.67 | 397.67 | 426.33 |
| 40 min | 3.00 | 9.00 | 12.00 | 5.33 | 154.33 | 159.67 |
| Times | Group 1 (in) | Group 1 (out) | Group 1 (Total) | Group 2 (in) | Group 2 (out) | Group 2 (Total) |
|---|---|---|---|---|---|---|
| 0 min | / | / | / | / | / | / |
| 5 min | 19.95 | 18.39 | 18.72 | 15.22 | 8.32 | 9.80 |
| 10 min | 49.87 | 50.30 | 50.21 | 48.16 | 31.20 | 34.82 |
| 20 min | 82.94 | 78.98 | 79.82 | 75.20 | 42.05 | 49.12 |
| 30 min | 96.19 | 94.91 | 95.19 | 88.71 | 57.56 | 64.20 |
| 40 min | 98.82 | 99.04 | 98.99 | 97.90 | 83.53 | 86.59 |
Publisher’s Note: MDPI stays neutral with regard to jurisdictional claims in published maps and institutional affiliations. |
© 2022 by the authors. Licensee MDPI, Basel, Switzerland. This article is an open access article distributed under the terms and conditions of the Creative Commons Attribution (CC BY) license (https://creativecommons.org/licenses/by/4.0/).
Share and Cite
Guan, Z.; Liu, P.; Zhou, T.; Zhou, L.; Zhang, D.; Xie, Q.; Yu, Q.; He, Y.; Wang, S.; Wang, X.; et al. Study on the Light Field Regulation of UVC-LED Disinfection for Cold Chain Transportation. Appl. Sci. 2022, 12, 1285. https://doi.org/10.3390/app12031285
Guan Z, Liu P, Zhou T, Zhou L, Zhang D, Xie Q, Yu Q, He Y, Wang S, Wang X, et al. Study on the Light Field Regulation of UVC-LED Disinfection for Cold Chain Transportation. Applied Sciences. 2022; 12(3):1285. https://doi.org/10.3390/app12031285
Chicago/Turabian StyleGuan, Zuwei, Peng Liu, Tianfeng Zhou, Lin Zhou, Danmei Zhang, Qiuchen Xie, Qian Yu, Yupeng He, Sijiang Wang, Xibin Wang, and et al. 2022. "Study on the Light Field Regulation of UVC-LED Disinfection for Cold Chain Transportation" Applied Sciences 12, no. 3: 1285. https://doi.org/10.3390/app12031285
APA StyleGuan, Z., Liu, P., Zhou, T., Zhou, L., Zhang, D., Xie, Q., Yu, Q., He, Y., Wang, S., Wang, X., & Zhao, W. (2022). Study on the Light Field Regulation of UVC-LED Disinfection for Cold Chain Transportation. Applied Sciences, 12(3), 1285. https://doi.org/10.3390/app12031285
